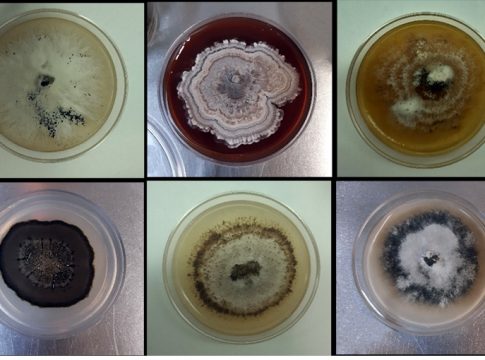
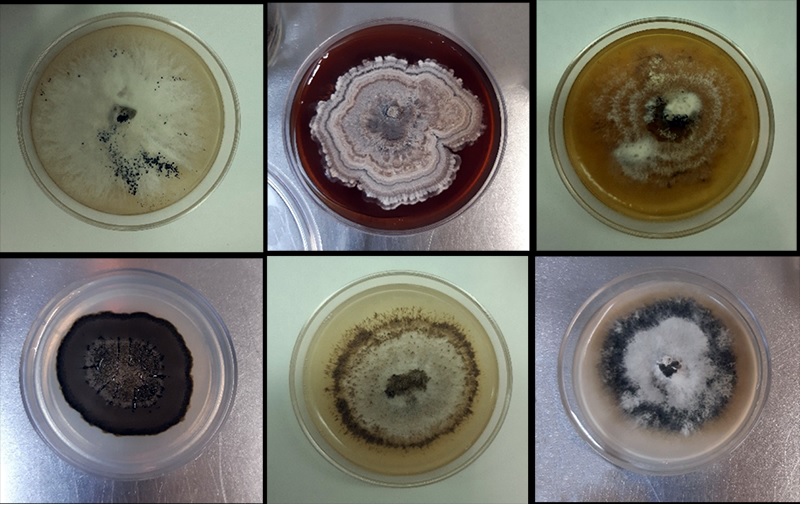

Una investigación del Consejo Superior de Investigaciones (CSIC), liderada por el grupo de Brásicas de la Misión Biológica de Galicia (MBG), ha revelado que los hongos endófitos de la berza tienen un efecto positivo en su cultivo.
El grupo de investigación de Brásicas de la MBG, en colaboración con el Instituto de Recursos Naturales y Agrobiología de Salamanca (IRNASA), ha publicado en la revista 'Scientific Reports' losresultados de este estudio acerca de los hongos endófitos, microorganismos que viven dentro de las plantas, en este caso la berza.
"Se sabe que estos hongos, que serían algo similar a nuestras bacterias intestinales, habitan dentro de los cultivos y les aportan nutrientes, les ayudan a defenderse contra animales herbívoros o patógenos o contribuyen a una mayor tolerancia frente a condiciones ambientales adversas", explica Pablo Velasco Pazos, científico titular del CSIC, quien añade que "por el momento, no se ha estudiado demasiado sobre la diversidad de estos hongos, y hasta la fecha no había ningún estudio relacionado con la berza", destaca Velasco.
En primer lugar, el grupo de investigación aisló de las raíces de berza una amplia variedad de estos hongos. Posteriormente, a partir de las raíces de cinco variedades locales de este cultivo, obtuvo más de 300 hongos aislados que, tras estudios morfológicos y moleculares, agruparon en 30 especies distintas.
"Se observó que de los 30, dos estaban presentes en las cinco variedades y la mayoría sólo en una de ellas, lo que revela la gran diversidad y variabilidad de estos microorganismos", apunta Pablo Velasco.
En segundo lugar, de los 30 hongos, seleccionaron 10 para estudiar su potencial uso en la mejora del cultivo, lo que implicó inocularlos nuevamente en las raíces de la berza y comprobar sus efectos en la planta.
"Hemos identificado un grupo de unos cinco hongos que, tal y como se ha puesto de manifiesto a través de ensayos en invernadero, incrementan el crecimiento y desarrollo de la berza, incluso en condiciones de frío", destacan los investigadores.
Asimismo, señalan que hay otro grupo de hongos que, frente a plantas de berza infectadas con una bacteria y con larvas de la oruga de la col, "aumentaban su capacidad para defenderse tanto del patógeno como del insecto herbívoro".
La jefa del grupo de investigación, Elena Cartea, asegura que con este estudio "se abren resultados prometedores" en esta línea iniciada en 2016 por Pablo Velasco Pazos. "Los siguientes pasos serán profundizar en el conocimiento de estos hongos y en determinar cómo son capaces de vivir en las raíces de las brásicas y de mejorar su cultivo. Para ello, estamos solicitando nuevos proyectos en convocatorias de concurrencia competitiva", apunta Cartea.
La investigación se ha desarrollado en el marco del proyecto 'Metabolitos secundarios en Brassicaceae: implicaciones en la mejora genética y resistencia a estreses', financiado por la Agencia Estatal de Investigación.